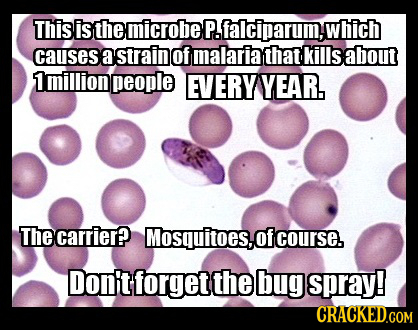
This is the microbe P.falciparuim, which causes a strain of malaria that kills about 1million people EVERY YEAR. The carrier? Mosquitoes,o of course.

26 Microscopic Horrors In and Around Your House Right Now
We get scared of things like shark attacks, bear maulings, or having to wipe with single ply toilet paper, but it turns out the real terror is that which can't be seen by the naked eye.
We get scared of things like shark attacks, bear maulings, or having to wipe with single ply toilet paper, but it turns out the real terror is that which can't be seen by the naked eye.
Our readers have compiled some of the tiniest terrors imaginable that are probably crawling on you right now. The winner is below, but first the runners-up ...







![Pictured above are cryptosporidium known to cause cryptosporidiosis] and giardia known to cause giardiasis] respectively. City tap water infrastructur](https://s3.crackedcdn.com/phpimages/pictofact/3/2/5/280325.jpg?v=1)